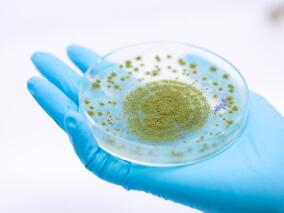
新冠肺炎相关毛霉菌病知多少?最新系统评价来了…

-
HIV/AIDS患者易患癌?这一类型癌症风险却降低1/4
环球医学资讯
2022年01月12日
点击量:226
1小时条评论通常,人类免疫缺陷病毒(HIV)/获得性免疫缺陷综合征(AIDS)患者比普通人更易患癌,但也有例外。 2021年3月,发表在《Prostate Cancer Prostatic Dis》的一项荟萃分析再次提示,HIV/AIDS男性患者前列腺癌发病率,比普通人群低约1/4。 HIV/AIDS患者易患癌 前列腺...
-
英国抗生素管理干预措施可改善抗生素耐药性
环球医学资讯
2022年01月11日
点击量:199
1小时条评论为了控制抗生素耐药性,在初级保健环境中已经引入了针对抗生素处方的抗菌药物管理干预措施。2021年12月,发表在《Lancet Infect Dis》的一项研究提示,仅实施该干预不足以抑制抗生素耐药。 背景:因抗生素过度使用造成的抗生素耐药是全球主要的健康问题。该研究旨在...
-
全球移民潜伏性结核病感染治疗的启动和完成情况如何?
环球医学资讯
2022年01月10日
点击量:275
1小时条评论全球约25%的人口有潜伏性肺结核感染(LTBI),约5%~15%的感染者在其一生中将进展为活动性结核病。2021年12月,英国、丹麦、荷兰等国学者发表在《Lancet Infect Dis》的一项系统评价和Meta分析,评估了全球移民潜伏性结核病感染治疗的启动和完成情况。 背景:LTBI是...
-
健康儿童和青少年接种SARS-CoV-2灭活疫苗 这个可以有
环球医学资讯
2022年01月07日
点击量:170
1小时条评论与成人相比,SARS-CoV-2儿童和青少年感染者大多轻微或无症状,但相对小数量的儿童和青少年可能处于严重COVID-19的风险中,尤其是具有潜在合并症者。2021年12月,中国学者发表在《Lancet Infect Dis》的一项双盲、随机对照、1/2期临床试验,评价了SARS-CoV-2灭活疫苗...
-
HIV感染者衰老加速 或因治疗不及时端粒长度缩短
环球医学资讯
2022年01月07日
点击量:330
1小时条评论在普通人群中,端粒长度缩短是衰老的标志,很多老年病也和端粒变短有关。2021年12月,瑞士、荷兰和西班牙学者发表在《J Infect Dis》的一项超过17年的纵向研究表明,在HIV感染者(PWH)中,如果未及时启动抗逆转录病毒治疗(ART),端粒长度明显缩短,成功病毒抑制后...
-
HIV/AIDS患者致泻性十二指肠贾第鞭毛虫病的全球流行…
环球医学资讯
2022年01月05日
点击量:175
1小时条评论十二指肠贾第虫是腹泻的主要原因之一,主要发生在非洲和亚洲的不发达国家。本系统评价和荟萃分析提供了关于HIV/AIDS患者贾第鞭毛虫病流行率、比值比(ORs)和相关风险因素的见解,相关内容发表在2021年11月的《Microb Pathog》上。 研究人员检索4个主要的英文数据库...
-
中国儿童侵袭性肺炎球菌病 近45%针对性治疗抗生素处…
环球医学资讯
2022年01月04日
点击量:173
1小时条评论世卫组织曾发出警告:今天滥用抗生素,明天将无药可用!合理使用抗生素,刻不容缓。2021年11月,发表在《BMC Infect Dis》的一项研究显示,中国侵袭性肺炎球菌病(IPD)儿童碳青霉烯类、万古霉素或利奈唑胺不合理使用的情况较为普遍。 背景:肺炎链球菌是儿童细菌性...
-
中国79个ICU中心导管相关血流感染率 与发达国家不相…
环球医学资讯
2022年01月04日
点击量:1542
1小时条评论中国尚未建立诸如美国NHSN的全国监测网络,因此对于中心导管相关血流感染(CLABSI)发生率还未进行过大样本调查。2021年12月,发表在《BMC Infect Dis》的一项前瞻性多中心研究填补了这一空白。结果发现,中国ICU的平均CLABSI发生率与发达国家相似,但地区间差异较大...
-
新冠肺炎相关毛霉菌病知多少?最新系统评价来了…
环球医学资讯
2021年12月31日
点击量:175
1小时条评论随着COVID-19的持续肆虐,机会性真菌感染的数量急剧增加。其中包括COVID-19相关毛霉病(CAM)。2021年12月,发表在《Mycoses》的一项系统评价,提供了关于CAM的现有文献的最新总结。 随着新冠疫情的暴发,毛霉菌病病例数激增。多数病例都与新冠肺炎具有时间相关性,...
-
多药耐药菌造成的老年尿路感染者 接受IEAT更频繁、…
环球医学资讯
2021年12月31日
点击量:232
1小时条评论多药耐药(MDR)菌对社区获得性尿路感染(UTI)老年住院患者中的临床影响仍不清楚。2021年12月,发表在《BMC Infect Dis》的一项研究对此进行了研究。 背景:既往研究已经描述了MDR菌在UTI中的一些风险因素。但是,MDR菌对社区获得性UTI老年住院患者中的临床影响还...

会员登录

